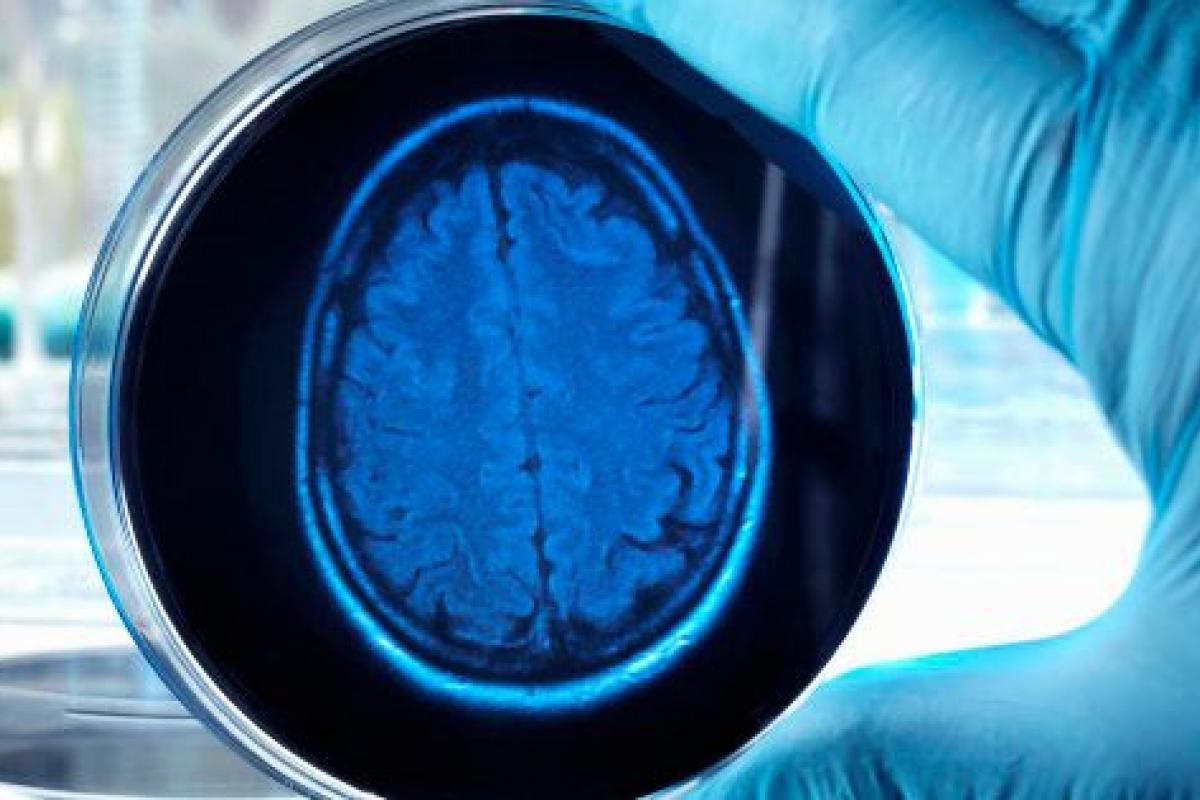

Tres variantes genéticas dan nuevas pistas contra el Alzheimer
Una investigación señala a las células inmunes del cerebro y ha identificado tres variantes genéticas que podrían servir para luchar contra el Alzheimer.
El futuro de la lucha contra el Alzheimer puede pasar por el sistema inmune. Una investigación de la Universidad de Pensilvania (Estados Unidos) ha identificado tres nuevas variantes genéticas que apuntan a las células inmunes del cerebro en el desarrollo de esta enfermedad neurodegenerativa y que dan nuevas pistas para combatirla.
En concreto, según describen en la revista Nature Genetics, estos genes codifican tres proteínas que se encuentran en las microglias, unas células que son parte del sistema de respuesta ante lesiones cerebrales, según han visto tras analizar datos de más de 85.000 pacientes.
El objetivo del estudio era identificar nuevas dianas terapéuticas para el tratamiento o la prevención del Alzheimer, y de hecho si consiguen diseñar medicamentos dirigidos contra estas variantes tendrán la "oportunidad de alterar el riesgo de esta enfermedad", ha apuntado Gerard Schellenberg, principal autor de la investigación.
TRES VARIANTES RARAS
"Se sabe desde hace décadas que las microglias rodean los depósitos de placa amiloide asociados con la enfermedad", ha añadido este experto, de ahí que estas variantes genéticas sean "la demostración más clara de que estas células son parte del Alzheimer y, lo que es más importante, proporcionan objetivos claros de proteínas en los que podemos comenzar a intervenir con fármacos".
Las tres variantes encontradas por Schellenberg y su equipo en los genes PLCG2, ABI3 y TREM2 son mutaciones que codifican proteínas en genes que están altamente expresados en las microglias y forman parte de una red de proteínas de células inmunes donde múltiples componentes contribuyen al riesgo de Alzheimer. Y uno de ellos, el PLCG2, es una enzima que es ya el objetivo de un fármaco en desarrollo.
Las tres son bastante raras, lo que explica el éxito de haberlas encontrado en su estudio en tres etapas. En la primera se codificaron todas las regiones codificadoras de proteínas de 34.290 muestras, y en la segunda y tercera el equipo refinó aún más las secuencias de variantes y verificó si eran significativas.
Pese al hallazgo, los autores creen que siguen existiendo preguntas clave sobre cómo deben atacar las microglias, si la respuesta a la lesión debe ser inhibida o activada y en qué fase de la enfermedad. "Debido a que la prevención es un objetivo clave de la terapia, es necesario explorar las células microgliales antes del inicio de los cambios cognitivos", dijo Schellenberg.















